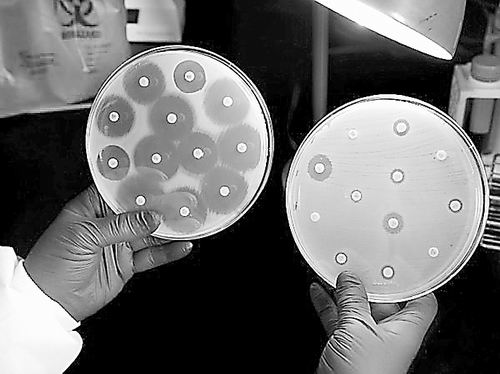

原标题:美设巨奖应对超级细菌
耐碳青霉烯类肠杆菌 图片来源:JAMES GATHANY/CDC
在对抗耐药性细菌的战斗中,美国政府出台了一个新激励措施:设置2000万美元奖金,用于奖励能识别高耐药性感染的快速诊断试验。该奖金只是白宫近日宣布的大量行动中的一个,这些行动标志着其对耐抗生素细菌威胁的更大关注。
除了相关奖金,美国政府还宣布了一项国家策略,设定了2020年需要达成的目标,包括更好地监督高耐药性感染、更快地发展新抗生素以及更好地使用现存药物。总统巴拉克·奥巴马还签署了一项行政命令,要求成立非政府专家组成的咨询小组委员会以及一个跨部门的特别小组,由健康和人类服务部(HHS)、国防部和农业部部长联合担任组长。
“这代表了该议题的一个重要高度,行政职能的主要累加作用将帮助解决该问题。”白宫科学和政策办公室主任John Holdren在新闻发布会上表示。
该奖金由国立卫生研究院以及生物医学高级研究和发展局联合赞助,它还将是一个即将召开的公共会议的主题,会上HHS将要求对最有用的检测方法进行反馈。
同时,总统科学和技术咨询委员会(PCAST)发布其观点以迎合一些广泛的目标。例如,他们就阻止抗生素耐药性工作的报告表明,一个实验室国家网络追踪高耐药性案例以及广泛使用基因分析调查耐药菌株,将会是一个突破点。他们还督促食品药品监督管理局制定新的批准路径,处理抗菌剂的迫切需求。更具体的建议是:在未来7年中,政府每年提供1.5亿美元用于可能带来新抗生素或对抗感染的“非常规”疗法的基础研究。
当然,政府部门并非必须做这些事情。Holdren表示,新成立的特别小组将会处理PCAST报告提出的建议,但并不一定接纳它们。另外,特别小组将于明年2月15日后提出自己的行动计划。(张章 中国科学报)
编辑:郭方园(实习生)、马丽
新闻来源:http://scitech.people.com.cn/n/2014/0924/c1007-25723896.html

留言